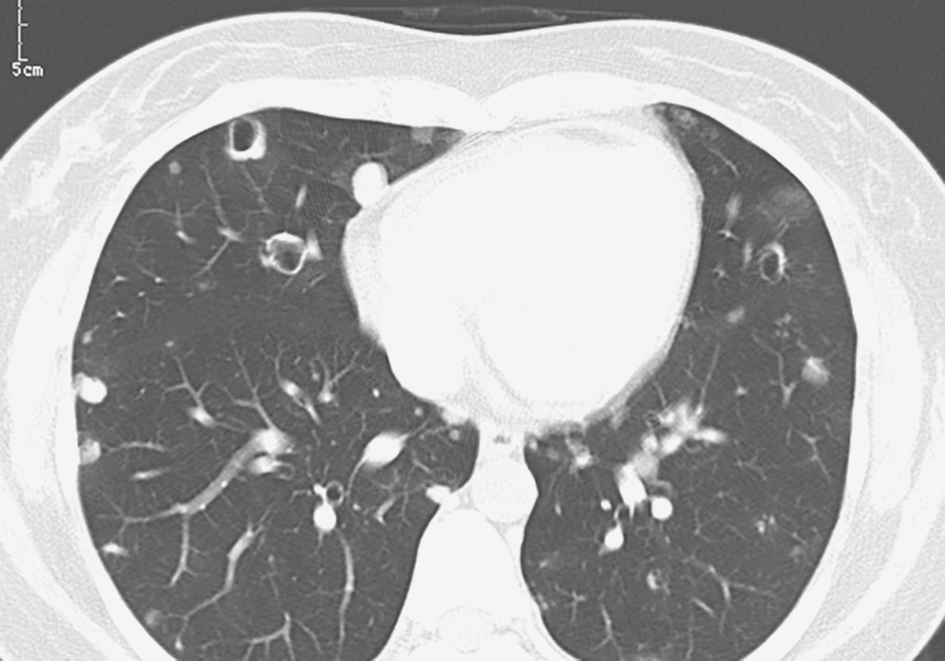

一例肺毛霉菌病诊治经验分享
54岁男性,50天前开始咳嗽、咳黄痰,病程后期有发热,双肺可闻湿啰音。影像学可见双肺多发片状密度增高影,伴有空洞形成,且短时间内影像学改变明显,由多发斑片影发展为多发空洞,继而出现局部肺不张及实变。需要做哪些检查以明确病因?
一、入院疑诊
(一)病例信息
【病史】
男性患者,54岁。患者于50天前,无明显诱因出现咳嗽、黄痰不易咳出(量中等),无胸痛、咯血及明显呼吸困难,于当地医院就诊,肺CT检查提示双肺多发斑片状密度增高影,初步诊断为社区获得性肺炎,经抗感染(左氧氟沙星和头孢呋辛等)及对症治疗后病情未见明显好转,仍咳嗽、咳黄痰。1个月前复查肺CT提示双肺多发斑片影伴空洞形成,疑诊为肺结核,应用试验性抗结核(利福平联合异烟肼)治疗1周后,因胃肠道不良反应,患者自行停药,之后仍有明显咳嗽、咳黄痰。18天前,复查胸部CT见右肺中叶区出现肺不张,左肺上叶原空洞部位出现部分实变。患者继续于当地医院行抗感染治疗(头孢菌素类,具体不详),但咳嗽、咳黄痰未见减轻。3天前,患者出现发热,体温最高达38.8℃,无明显寒战,发热时间不规律,口服退热药后体温可降至正常,但有反复,为进一步诊治收入院。病程中,患者无腹痛、腹泻,无头痛、头晕,无关节肿痛等不适;饮食尚可,大小便无异常,体重无明显变化。
患者发现血糖升高50天,未系统治疗;否认犬类、牛羊等动物接触史;近期未到过传染病疫区;职业为教师;无吸烟及饮酒嗜好。
【体格检查】
体温36.6℃,心率84次/min,呼吸18次/min,血压120/80mmHg。双肺叩诊呈清音,双肺呼吸音粗糙,双上肺可闻湿啰音,未闻胸膜摩擦音。心律齐,未闻心脏病理性杂音及心包摩擦音。腹部查体未见明显异常。双侧下肢无水肿。
【实验室检查】
白细胞总数9.7×109/L,单核细胞百分比10.9%,单核细胞计数1.1×109/L。
真菌G试验结果为阴性。
免疫常规检查结果为阴性。
空腹血糖7.89mmol/L,糖化血红蛋白(HbA1c)8.4%。
肝、肾功能正常。
【影像学检查】
入院前两次胸部CT表现见图1、图2。

图1 发病第20天胸部CT表现
胸部CT可见双肺片状高密度影及多发空洞形成,伴右肺中叶膨胀不全


图2 发病第32天胸部CT表现
胸部CT可见右肺中叶区不张,左肺上叶原空洞部位出现部分实变
(二)临床思辨
【临床特点】
1.患者为中年男性,病程50天。
2.主要症状和体征为咳嗽、咳黄痰,病程后期有发热,双肺可闻湿啰音。
3.实验室检查示血常规白细胞大致正常,单核细胞略增高,血糖轻度升高。
4.影像学可见双肺多发片状密度增高影,伴有空洞形成,且短时间内影像学改变明显,由多发斑片影发展为多发空洞,继而出现局部肺不张及实变。
5.发病50天过程中,患者先后经多种抗感染治疗(氟喹诺酮类、头孢菌素类及抗结核药物等),咳嗽、咳痰未见好转,且出现发热,肺内病变变化明显,治疗无效。
【思辨要点】
本例患者主要症状为咳嗽、咳黄痰,早期无发热,本次入院前出现发热。可以导致咳嗽、咳黄痰的呼吸道疾病主要以感染性疾病为主,包括细菌性肺炎、支气管扩张症、肺结核、肺部肿瘤合并感染及慢性支气管炎急性加重或其他肺部疾病继发感染等。单纯从症状分析对诊断缺乏特异性,需要结合患者的病程、实验室检查、影像学检查及治疗反应进行分析。
对于咳嗽、咳痰,发病初期肺部CT出现双肺多发斑片影的患者,需首先考虑常见病、多发病——肺部感染性疾病(包括感染类型和可能病原体)。
1.从感染场所分析可能的病原体
根据患者发病时的环境因素,考虑为社区获得性肺炎,同时仔细追问病史,亦未查找到患者可能出现特殊感染的环境因素,如结核患者接触史、潮湿发霉环境、牛羊接触史及疫区接触史等,因此在发病早期,可以考虑为社区获得性肺炎(CAP)。CAP常见病原体有肺炎链球菌、流感嗜血杆菌、卡他莫拉菌、支原体等非典型病原体以及普通病毒等,氟喹诺酮类、二/三代头孢菌素治疗应有效。但本例患者经上述抗感染药物治疗,效果不理想,说明所用抗感染药物未覆盖感染病原(包括细菌、病毒和真菌)或为混合感染及耐药菌感染。因此,本病例为单一病原所致社区获得性肺炎的可能性不大,须明确是否存在革兰阴性杆菌、肠球菌、耐甲氧西林金黄色葡萄球菌、多耐药/广泛耐药/全耐药菌等感染以及真菌感染、病毒感染、结核分枝杆菌等特殊致病菌感染。
2.从胸部影像学特征分析可能的病原
本例患者起病后,胸部影像变化迅速,从初期双肺多发斑片影迅速进展,出现多发空洞,继而出现局部肺不张和实变。可引起空洞形成的常见肺部疾病有肺脓肿、肺结核和侵袭性肺真菌病等,其他还有寄生虫感染、肺囊肿合并感染、癌性空洞等。
(1)肺脓肿
可为吸入性肺脓肿、血源性肺脓肿及继发性肺脓肿。吸入性肺脓肿多为单发,伴有咳脓臭痰、高热。血源性肺脓肿多由细菌血行播散所致,常见于金黄色葡萄球菌败血症,可表现为多发小的薄壁空洞,即液气囊腔(图3),可进展迅速,常伴有发热。继发性肺脓肿可为肺炎后肺脓肿、阿米巴性肺脓肿等,多为单发空洞。
(2)肺结核
肺结核空洞常为厚壁空洞,周围可有肉芽肿性肺实变、纤维化或钙化区,可伴有卫星灶或树芽征(图4)。患者可有乏力、低热、盗汗等结核中毒症状,或临床症状不典型。

图3 金黄色葡萄球菌败血症所致肺脓肿胸部CT表现

图4 肺结核空洞胸部CT表现
胸部CT见周围卫星灶及树芽征
(3)肺真菌病
包括球孢子菌病、肺曲霉菌病、肺隐球菌病等,可导致肺部空洞形成,但胸部CT影像学表现缺乏特异性。典型的肺曲霉菌病可表现为晕征、空气新月征、曲霉菌球(图5);肺隐球菌病可出现肺实变、肿块及胸膜下结节影,其内可出现空洞(图6)。

图5 肺曲霉菌病胸部CT表现
胸部CT见双肺多发空洞,左肺空洞内可见曲霉菌球

图6 肺隐球菌病胸部CT表现
胸部CT见双肺多发结节影,其内可见小空洞,右下肺近胸膜处空洞明显
(4)癌性空洞
原发支气管肺癌发生空洞最多见于鳞癌,其次为腺癌和大细胞癌,小细胞癌一般不发生空洞。癌性空洞一般为单发空洞,洞壁多为厚壁或厚薄不均,洞壁不光滑(图7)。支气管肺泡癌可出现多发薄壁囊性空洞。转移癌性空洞可为多发,囊性、薄壁(图8),男性多为头颈部肿瘤转移,女性多为生殖系统肿瘤转移所致,原发肺癌发生空洞性肺转移者少见。

图7 癌性空洞胸部CT表现
胸部CT见右下肺空洞,壁厚且内壁不光滑,伴气液平和局部肺门肿大
图8 肺转移癌性空洞胸部CT表现
胸部CT见双肺多发空洞
(5)其他疾病
硅沉着病、风湿免疫病肺损伤(如类风湿肺)及肉芽肿性血管炎等也可导致肺部空洞形成。
3.从宿主易感因素分析可能的病原
患者既往身体健康,但此次发病时发现血糖偏高,入院后检查HbA1c增高,糖尿病诊断明确,为感染的高危因素,易发生结核分枝杆菌和真菌等感染,须对之加以鉴别。
本例患者以咳嗽、咳痰为主要症状,发热不明显,无明显乏力、盗汗、体重减轻,症状相对较轻,不符合急性肺脓肿及金黄色葡萄球菌脓毒血症的表现,考虑单纯肺脓肿可能性不大。其胸部影像学改变迅速,且为双肺多发空洞性病变,考虑原发支气管肺癌可能性不大。患者既往无粉尘及职业接触史,硅沉着病基本可以排除。病毒感染多为自限性,且影像学表现一般为双肺弥漫间质性改变,很少出现空洞性病变,因此本病例为病毒感染可能性不大。患者既往无风湿性疾病病史,无关节肿痛、皮肤改变等症状,考虑风湿性疾病可能性不大,可进行相关检查以排除。虽然患者曾使用1周抗结核药物,但用药时间较短,难以评价治疗反应。因此,对于本病例,目前尚不能排除的疾病有耐药菌及混合细菌感染、肺结核、肺真菌病和肉芽肿性血管炎等。此外,由于本病例病程较长,期间应用多种抗感染药物治疗,但疗效不明显,除了肺部感染性疾病,还要考虑其他可能的疾病,须进一步完善相关检查,以明确病原菌,同时排除非感染性因素。
二、诊治过程
(一)临床信息
【实验室检查】
1.一般检查
(1)血常规(多次检查):白细胞及中性粒细胞在正常范围内,血红蛋白和血小板均正常。
(2)红细胞沉降率正常。
(3)肝肾功能及电解质正常。
(4)入院后经胰岛素治疗,空腹血糖控制在6.0~7.5mmol/L。
2.免疫相关检查
自身抗体(包括抗核抗体、抗dsDNA、Sm抗体、抗线粒体抗体等)阴性,ANCA均阴性。
3.感染相关血液检查
T淋巴细胞刺激γ-干扰素释放试验(T-SPOT)阴性,病原血清抗体(包括鼻病毒、柯萨奇病毒、EB病毒、巨细胞病毒、腺病毒、呼吸道合胞病毒、流感病毒、肺炎支原体、肺炎衣原体、军团杆菌等)均阴性,真菌检测(G试验和GM试验)均阴性。
4.痰检测
痰抗酸杆菌阴性,痰培养未检出致病菌,痰脱落细胞未查到癌细胞。
【支气管镜检查】
入院第4天支气管镜检查:内镜下见右肺中叶及上叶尖段、前段气道黏膜充血、肿胀,管腔狭窄,脓性分泌物阻塞管腔(图9)。支气管肺泡灌洗液涂片可见少量真菌。送检组织(右肺中叶)病理检查见大量真菌菌团,并有炎性渗出物。

图9 入院第4天支气管镜检查镜下所见
【影像学检查】
胸部CT见双肺多发片状密度增高影,伴多发空洞形成,并见局限性肺不张及实变。
【治疗过程】
入院后,给予哌拉西林舒巴坦5.0g(每天3次)静脉滴注;因支气管肺泡灌洗液及肺组织病理均查到真菌,考虑侵袭性肺真菌病(最常见为曲霉菌感染)可能性大,遂静脉给予三唑类抗真菌药伏立康唑治疗。
(二)临床思辨
对于本病例,根据患者的症状、病史及胸部影像学检查结果,诊断应重点考虑耐药菌、特殊菌及真菌感染,并思考以下问题:
1.在明确病原体之前,是否继续经验性抗感染治疗?
本例患者在入院前曾使用过多种抗感染药物,包括二/三代头孢菌素、氟喹诺酮类等,但疗效欠佳,故考虑患者可能存在特殊菌,如结核分枝杆菌及真菌感染的可能。但患者反复咳嗽、咳黄痰,不能排除在特殊菌感染基础上合并有其他细菌感染,因此在明确病原体之前仍可继续经验性抗感染治疗。但更重要的是尽快鉴定感染病原,以实现目标性抗感染治疗。
2.对于本例患者,需要做哪些检查以明确病因?
首先,可以通过无创和有创手段获得标本,明确感染性因素,确定感染病原;其次,进行可明确或排除其他非感染性疾病的相关检查。
(1)确定感染病原的相关检查
通过无创手段获得的标本主要包括血液及呼吸道分泌物(痰液及支气管肺泡灌洗液)。对于血液,可通过分子生物学核酸检测、抗原抗体检测及机体病原免疫反应检测等方法检测相关病毒抗体、肺炎支原体抗体、PPD、T-SPOT及真菌G试验和GM试验等。痰液及支气管肺泡灌洗液可以通过培养及涂片抗酸染色明确致病菌。本病例血液检查未发现阳性结果,支气管肺泡灌洗液中发现真菌,对诊断有一定意义,但须明确为哪一种真菌。
通过有创手段获取标本包括纤维支气管镜下黏膜活检或经支气管肺活检(TBLB)、CT引导下穿刺、B超引导下穿刺、气道超声内镜引导下穿刺和外科胸腔镜手术等。本例患者肺部CT表现为双肺多发病灶,有空洞形成,也有不张及实变,右肺中叶管腔狭窄、阻塞,可以通过纤维支气管镜检查来取得病理标本,这对于明确诊断具有至关重要的作用。肺组织病理结果可见大量真菌菌团,结合支气管肺泡灌洗液结果可诊断肺真菌感染,但仍需进一步明确具体种类。
(2)排除其他可能疾病的相关检查
入院后经完善有关风湿性疾病及血管炎等相关检查,未发现阳性结果,且肺组织病理未发现肉芽肿性改变,基本可排除这两类疾病的可能性。痰脱落细胞和肺组织病理也未见肿瘤的相关证据,故可排除之。
综合以上资料,本病例侵袭性肺真菌病诊断明确,根据经验考虑最常见为曲霉菌感染,给予伏立康唑治疗,继续观察患者症状和胸部影像学变化,明确其疗效。
三、临床确诊
(一)临床信息
患者入院后,经伏立康唑治疗,病情好转,咳嗽、咳痰症状减轻,体温降至正常,但仍有黄痰。
【影像学检查】
经伏立康唑抗真菌治疗7天后,复查胸部CT见右肺中叶病灶有所吸收(图10)。

图10 治疗后复查胸部CT表现
【支气管镜检查】
经伏立康唑治疗13天后,为了进一步明确真菌类型,了解管腔阻塞是否缓解,遂行第2次支气管镜检查。支气管镜下见右上叶前段、右下叶前、外侧基底段支气管开口处黄绿色胶冻样分泌物阻塞管腔,局部支气管黏膜充血水肿,伴肉芽组织增生(图11)。病理检查(右下叶前段),显微镜下可见真菌,菌丝表现为粗大、无分隔,分叉角度近似直角(图12),考虑为毛霉菌。
最后诊断:肺毛霉菌病。
确诊肺毛霉菌病后,用药改为两性霉素B联合氟胞嘧啶。治疗过程中复查肺部CT显示治疗效果较好,但病变吸收较缓慢,需较长疗程。治疗5个月后复查肺部CT发现病灶(左肺上叶及右肺中叶)明显吸收(图13),继续使用两性霉素B联合氟胞嘧啶治疗。

图11 支气管镜检查镜下所见

图12 支气管管腔内组织活检病理表现(HE染色,100×)

图13 抗真菌治疗5个月后复查胸部CT表现
(二)临床思辨
本例患者发病初期症状为咳嗽、咳黄痰,这是呼吸系统疾病最常见的症状,通常考虑为感染性疾病,结合胸部CT见双肺多发斑片影,初始诊断为社区获得性肺炎。但经过经验性抗感染治疗,患者症状未见缓解,且胸部影像学改变迅速,出现多发空洞,使得病情变得复杂化,但试验性抗结核治疗的时间较短,无法评价其疗效。入院后,结合患者的基础疾病及抗感染治疗效果不好等特点,考虑为真菌感染,并通过支气管镜检查等无创及有创手段获取标本进行相关检查,根据病理结果最终诊断为肺毛霉菌病,制订针对毛霉菌感染的治疗方案,使患者的病情得到明显改善。
回顾本例患者的诊治过程,应思考以下问题:
1.抗感染治疗无效时,如何考虑诊断?
本例患者既往健康,职业为教师,无特殊接触史,因此在患病早期很容易被诊断为社区获得性肺炎,但经过较长时间的经验性抗感染治疗,效果并不理想。此时,应对诊断打个问号,并更加仔细地寻找其他导致病变的原因,包括患者的居住环境、嗜好、近期有无疫区旅游等一切可以导致特殊病原体感染的因素。在确定患者血糖高后,还要将一些特殊菌,如结核分枝杆菌及真菌感染纳入疑诊范围。本例患者在入院前曾被疑诊为肺结核,这个诊断思路是正确的,但试验性抗结核治疗的时间较短,无法评价其疗效。本例患者之前未能进行支气管镜检查等有创检查明确病原,导致确诊时间延长,这提示临床医师,对于这样一个影像学改变迅速且出现空洞的患者,应尽早进行病原学检查,因为明确病原体的种类对于有目的性的抗感染治疗是至关重要的。
2.哪些病原体感染可导致胸部影像学表现为多发空洞且进展迅速?
本例患者肺部CT表现多样,在短时间内出现较大的变化,由最初的多发斑片影发展为多发空洞,继而出现不张及实变,说明致病菌有较强的侵袭性,可见于真菌感染,如曲霉菌、毛霉菌感染,临床较多见的为曲霉菌感染。另外,结核分枝杆菌感染也可出现空洞,但出现两肺多发空洞且进展迅速者也不多见。本病例病理检查结果证实为毛霉菌感染。
3.宿主因素对感染病原体有什么影响?
本例患者既往身体健康,仔细追问病史得知其居住环境无潮湿及发霉环境,未接触过发霉物质(如取暖用的秸秆等),因此在发病初期未考虑真菌感染的可能。但患者血糖升高是机会致病菌感染的高危因素,因此无论患者有无特殊病原体的接触史,仍应将真菌感染纳入诊断范围。
4.肺毛霉菌病有哪些特点?
肺毛霉菌病在临床上较少见。毛霉菌可存在于正常人口腔和鼻咽部,属于机会致病菌。毛霉菌病分为肺型、鼻脑型、胃肠型、皮肤型、混合型及播散型,其高危因素包括糖尿病或合并酮症酸中毒、粒细胞缺乏、应用糖皮质激素和免疫抑制剂、恶性肿瘤(尤其血液系统恶性疾病)、肾功能衰竭、病毒性肝炎、实体器官移植术后、HIV感染等。本例患者患有未经控制的2型糖尿病,可导致免疫功能下降。
肺毛霉菌病的临床表现可为咳嗽、咳痰、发热、胸痛、呼吸困难、咯血等,其中以咳嗽、发热多见。需要注意的是,毛霉菌具有明显的血管侵袭性,可形成血栓和缺血性坏死,故高危患者出现血痰、咯血,应高度警惕该病。肺毛霉菌病的影像学表现主要为肺部斑片状渗出影、实变影、结节影、空洞样变等,可伴晕轮征(halo征)、新月征,增强胸部CT显示为边缘强化,偶伴胸腔积液。血常规可见白细胞计数及中性粒细胞计数升高。血清GM试验、真菌G试验结果常为阴性。痰液、针吸液及BALF培养阳性率<5%,血培养阳性率更低。由此可见,肺毛霉菌病的症状、体征及辅助检查均缺乏特异性,极易误诊为其他病原体感染,从而延误治疗。本例患者在病初被误诊为细菌性肺炎、肺结核和曲霉菌感染,最终经支气管镜检查明确了肺毛霉菌病的诊断。
确诊肺毛霉菌病可根据纤维支气管镜或经皮肺穿刺活检发现特征性菌丝和病理改变,或组织、无菌体液培养阳性。病理组织切片在显微镜下可见大量坏死组织,毛霉菌的菌丝表现为多核、宽大而无分隔,分支不规整且有一定角度(但不同于曲霉菌分支呈45°),毛霉菌菌丝多呈直角分叉。本病发病凶险、进展极快,病死率很高,生前确诊者不足50%,大部分病例在尸检时才得到确诊。早期诊断是患者得到有效治疗的关键因素之一。对于肺部感染使用广谱抗生素治疗2周以上、痰菌培养阴性而感染呈进行性加重且有发病高危因素的患者,应高度警惕肺毛霉菌病,有条件者尽早进行病理组织学检查以明确诊断,为治疗争取时间。
肺毛霉菌病的治疗主要包括抗真菌药物治疗和外科手术。另外,纠正电解质紊乱、控制血糖、减少免疫抑制剂用量等也对预后起到至关重要的作用。药物治疗首选静脉应用两性霉素B,与氟胞嘧啶(flucytosine,5-FC)联合应用有协同作用,且可减少两性霉素B用量以减小其毒性。由于毛霉菌极易阻塞局部血管和支气管,药物很难在病灶部位达到较高浓度,单纯内科治疗效果常不理想。若两性霉素B应用2周症状无改善,应尽早手术切除病灶。目前认为,手术联合药物治疗是最佳治疗方法,相对于单一药物治疗,可明显降低病死率。
精要回顾与启示
咳嗽、咳痰伴发热是呼吸系统感染性疾病最常见的症状。本例患者很容易被诊断为社区获得性肺炎。但在经验性抗感染治疗无效时,要及时思考治疗无效的原因,并尽早通过无创或有创手段得到病原学诊断,确定感染病原体种类,以保证能够有目的性地抗感染治疗,从而改善疾病预后。
在诊断疾病过程中,对于患者个体因素也须高度重视,尤其是对于有基础疾病(如糖尿病)、免疫功能低下(如器官移植后应用免疫抑制剂)、长期应用激素及抗生素治疗者,应考虑到机会致病菌感染。
肺毛霉菌病临床较少见,其血清GM试验和真菌G试验结果常为阴性,痰液、针吸液及BALF培养阳性率<5%,血培养阳性率更低,缺乏特异性,因此容易被误诊为其他病原体感染。肺毛霉菌病的确诊主要依靠支气管镜或经皮肺穿刺等方式活检发现特征性菌丝和病理改变,或组织、无菌体液培养阳性。这也提示临床医师早期通过有创检查明确感染病原体的重要性。
知识来源
人卫知识数字服务体系
- 评价此内容
- 我要打分
近期推荐
热门关键词
合作伙伴
Copyright g-medon.com All Rights Reserved 环球医学资讯 未经授权请勿转载!
网络实名:环球医学:京ICP备08004413号-2
关于我们|
我们的服务|版权及责任声明|联系我们
互联网药品信息服务资格证书(京)-经营性-2017-0027
互联网医疗保健信息服务复核同意书 京卫计网审[2015]第0344号




会员登录

